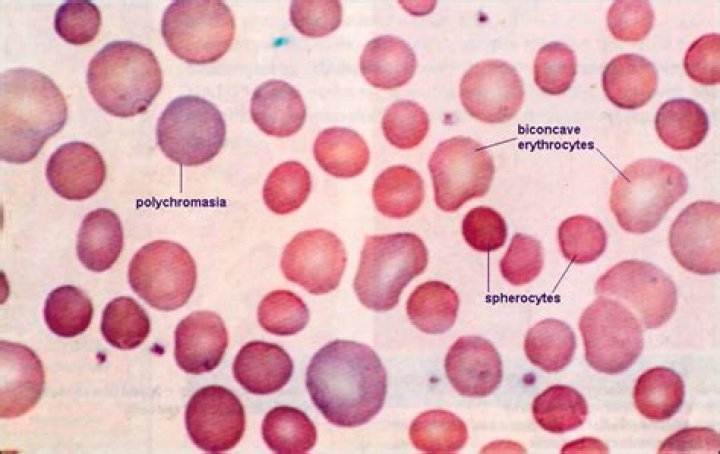
Cover

Hereditary spherocytosis is a condition that affects red blood cells. People with this condition typically experience a shortage of red blood cells (anemia ), yellowing of the eyes and skin (jaundice), and an enlarged spleen (splenomegaly).
What is the most accurate test for hereditary spherocytosis?
The combination of the eosin-5′-maleimide-binding test and acidified glycerol lysis test enabled all patients with hereditary spherocytosis to be identified. The eosin-5′-maleimide-binding test showed the greatest disease specificity.
What deficiency causes hereditary spherocytosis?
Spectrin deficiency is the most common defect in HS. The biochemical nature and the degree of spectrin deficiency are reported to correlate with the extent of spherocytosis, the degree of abnormality on osmotic fragility test results, and the severity of hemolysis.
Why is spherocytosis bad?
Some increase the flexibility of cells so they can easily travel from larger blood vessels to smaller, narrow blood vessels. The gene mutations that cause hereditary spherocytosis cause red blood cells to have an abnormal, spherical shape with decreased flexibility. The misshapen red blood cells are called spherocytes.
Can someone with spherocytosis donate blood?
As for Carson’s dad, he can’t donate blood because he too has spherocytosis, but he helps by coordinating blood drives at work. He understands that he and his son are proof that donated blood saves lives.
What are the symptoms of hereditary spherocytosis?
Hereditary spherocytosis (HS) is an inherited disease that affects the red blood cells. Characteristic symptoms of HS are the destruction of red blood cells in the spleen and their removal from the blood stream (hemolytic anemia), a yellow tone to the skin (jaundice), and an enlarged spleen (splenomegaly).
Can I donate blood if I have spherocytosis?
1. Must not donate if: Clinically significant haemolysis.
Does spherocytosis make you tired?
Fatigue may be a symptom of hereditary spherocytosis (HS), and is often associated with anemia in affected people.
How does hereditary spherocytosis affect the body?
Can you live with hereditary spherocytosis?
The irregular shape of the red blood cells can cause the spleen to break them down faster. This breakdown process is called hemolytic anemia. A normal red blood cell can live for up to 120 days, but red blood cell with hereditary spherocytosis might live for as few as 10 to 30 days.
What does spherocytosis mean?
Spherocytosis is an illness that causes a problem with red blood cells. The membrane or wall around the red blood cell is not normal.
What is the treatment for hereditary spherocytosis?
There are different types of hereditary spherocytosis, which are distinguished by severity and genetic cause. Depending on severity, treatment may involve splenectomy, red cell transfusions, folic acid supplementation, and/or cholecystectomy.
How can you tell if you have hereditary spherocytosis?
How is hereditary spherocytosis diagnosed? The changes in the red blood cell can be seen through a microscope. They will be noticed if a blood sample is sent to the laboratory. Another cell (a reticulocyte) may also be seen. This shows that the red blood cells are being broken down too quickly. Other blood tests are sometimes needed.
How is spherocytosis diagnosed in peripheral blood film?
Spherocytosis can be diagnosed in Peripheral blood film by seeing spherical red blood cells rather than biconcave. Because spherical red blood cells are more prone to lysis in water (because they lack some proteins in their cytoskeleton) there will be increased osmotic fragility on acidified glycerol lysis test.
What are some of the side effects of spherocytosis?
Complications of spherocytosis may include megaloblastic crisis, low folic acid levels, splenomegaly, and/or gallbladder problems. The prognosis for spherocytosis may be good to fair, depending upon the development of complications.
What does it mean to have sphere shaped red blood cells?
This article is about the presence of spheroid red blood cells. For the hereditary cause of this disorder, see Hereditary spherocytosis. Spherocytosis is the presence in the blood of spherocytes, i.e erythrocytes ( red blood cells) that are sphere-shaped rather than bi-concave disk shaped as normal.
How is hereditary spherocytosis diagnosed? The changes in the red blood cell can be seen through a microscope. They will be noticed if a blood sample is sent to the laboratory. Another cell (a reticulocyte) may also be seen. This shows that the red blood cells are being broken down too quickly. Other blood tests are sometimes needed.
What kind of blood test is used to check for spherocytosis?
The test is called a complete blood count, or CBC. The percent of immature red blood cells in the blood. These are called reticulocytes. The level is higher in people with spherocytosis. The shape of the red blood cells as seen under a microscope. Red blood cells that look round instead of flat are a sign of spherocytosis.
Complications of spherocytosis may include megaloblastic crisis, low folic acid levels, splenomegaly, and/or gallbladder problems. The prognosis for spherocytosis may be good to fair, depending upon the development of complications.
What causes red blood cells to be shaped like spheres?
Medically reviewed by Judith Marcin, MD, specialty in Family Medicine, on June 22, 2017 — Written by Carmella Wint. Hereditary spherocytosis (HS) is a disorder of the surface, called the membrane, of your red blood cells. It causes your red blood cells to be shaped like spheres instead of flattened discs that curve inward.